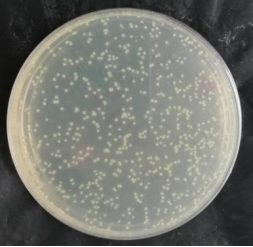
产品细节图片1

相关产品推荐更多 >
万千商家帮你免费找货
0 人在求购买到急需产品
- 详细信息
- 文献和实验
- 技术资料
- 保存条件:
负20℃
- 保质期:
六个月
- 库存:
10
- 供应商:
上海雅吉生物科技有限公司
- 规格:
300μl甘油菌
产品规格:300μl甘油菌
亲爱的科研工作者,感谢您信任雅吉生物,我们致力于为大家分享质优价适的质粒,受各种因素影响,我们只保证质粒的关键序列测序正确,不能保证实验效果。请您收到质粒后请务必先转化,再挑取单菌落扩增,不要直接使用。如果您需要即用的大包装质粒或病毒颗粒,可委托我们制备,性价比更高。
一、扩增流程
收到产品后,请先根据产品管壁标签来判断产品形式,并在扩增前准确查找该质粒菌株的抗性、感受态和培养温度。
1、质粒干粉
产品规格:0.5~2μg质粒干粉,保证能转化出来,不保证具体含量,请务必先转化进感受态,再挑单菌落提取后再使用。
保质期限:90天,请尽快转化。
保存温度:一般在-20°C,置于-80°C保存时间更长。
运输方式:常温运输,1周内。
注意事项:转化前请准确查找该质粒相应的抗性、抗性浓度、感受态名称和培养温度。(可向我司负责人QQ或微信索要)
使用说明:
1、收到质粒干粉后请先5000rpm离心1min,再加入20μl无菌水溶解质粒,室温放置1min;
2、从-80°C冰箱中取出相应的感受态,置于冰盒上解冻,并做好标记;
3、取2μl质粒加至100μl感受态中,冰浴30min;
4、42℃热激90s,再冰浴2min;
5、加入900μl无抗的LB液体培养基,180rpm震荡培养45min;
6、6000rpm离心5min,仅留100μl上清混匀菌体沉淀;
7、混匀后的菌液加至对应抗性的LB平板上,倒入适量玻璃珠,涂匀液体;
8、将平板正向培养1h,再倒置培养12h~16h;
9、挑取单克隆菌落至对应抗性的LB液体培养基中,震荡培养12h~16h,根据实验需要提取质粒。
注意:如果平板长的过多,请将质粒稀释后再转化;如果没有长菌落,请取10μl质粒转化。
不动杆菌(冰袋运输,存于-80℃,保质期90天,请务必划线挑单克隆培养)
产品规格:甘油菌种。
保质期限:90天,请尽快划线培养。
保存温度:-80℃。
运输方式:冰袋运输,1周内。
注意事项:培养前请准确查找该菌种的抗性、抗性浓度和培养温度。
使用说明:
1、收到甘油菌种后请甩动保存管,让菌液不要吸附在管壁上;
2、用接种环在固体平板上四区划线,如有抗性就加对应抗性;
3、恒温培养箱倒置培养12~16h;
4、挑取单菌落接种于液体培养基中,如有抗性就加对应抗性;
5、摇床震荡培养12~16h,根据实验需要保存甘油菌,酵母加30% 甘油,其它一般加15%甘油。
注意:务必要四区划线挑单菌落培养。
- 转化图片:
| ATCC25922大肠杆菌埃希菌 | 300μl甘油菌 | 大肠杆菌,大肠埃希菌 | 标准菌株 | |
| CMCC(B)44102大肠杆菌埃希菌 | 300μl甘油菌 | 大肠杆菌,大肠埃希菌 | 标准菌株 | |
| CMCC(B)26003 | 300μl甘油菌 | 标准菌株 | ||
| CMCC(B)10104绿脓杆菌铜绿假单胞菌 | 300μl甘油菌 | 绿脓杆菌,铜绿假单胞菌 | 标准菌株 | |
| ATCC27853绿脓杆菌铜绿假单胞菌 | 300μl甘油菌 | 绿脓杆菌,铜绿假单胞菌 | 标准菌株 | |
| ATCC16404巴西曲霉菌 | 300μl甘油菌 | 巴西曲霉菌 | 标准菌株 | |
| CMCC(B)54002单核增生李斯特 | 300μl甘油菌 |
风险提示:丁香通仅作为第三方平台,为商家信息发布提供平台空间。用户咨询产品时请注意保护个人信息及财产安全,合理判断,谨慎选购商品,商家和用户对交易行为负责。对于医疗器械类产品,请先查证核实企业经营资质和医疗器械产品注册证情况。
文献和实验,通常在纯培养,在实验室,这可能是无法实现的许多细菌物种。这种多相方法还依赖于DNA-DNA杂交等技术,这些技术费时费力,特别是与现代基因组测序的简易性相比。在高通量测序的最新进展的推动下,我们与其他研究人员一起,已经开始探索基因组序列数据对于细菌物种描述和分类的适用性。在我们最近的BMC微生物学出版物中,我们利用不动杆菌属探索基因组序列的比较分析是否可以与经典的DNA-DNA杂交和表型方法相媲美。迄今为止,共有27种不动杆菌被描述,包括新出现的病原体鲍曼不动杆菌。然而,鲍曼不动杆菌与其他三种不动杆菌
作者:雷金娥, 袁莉, 李和平, 马列婷, 王亚文, 曾晓艳 作者单位:西安交通大学医学院第一附属医院检验科,陕西西安 710061 【摘要】 目的 了解我院鲍曼不动杆菌的耐药性及其产金属β-内酰胺酶(MBLs)的情况。方法 采用K-B纸片扩散法测定13种抗菌药物的耐药性;分别用金属螯合剂乙二胺四乙酸(EDTA)和2-巯基丙酸抑制试验测定鲍曼不动杆菌产金属β-内酰胺酶的情况。结果 91株鲍曼不动杆菌中有23株对亚胺培南耐药,其仅对阿米卡星和米诺环素耐药率较低
Abiotrophia adjacens 毗邻贫养菌 Abiotrophia defectiva 软弱贫养菌 Achromobacter spp 无色杆菌属某些种 Acinetobacter /Pseudomonas spp 不动杆菌/假单胞菌属某些种 Acinetobacter baumannii 鲍氏不动杆菌 Acinetobacter calcoaceticus
技术资料暂无技术资料 索取技术资料









